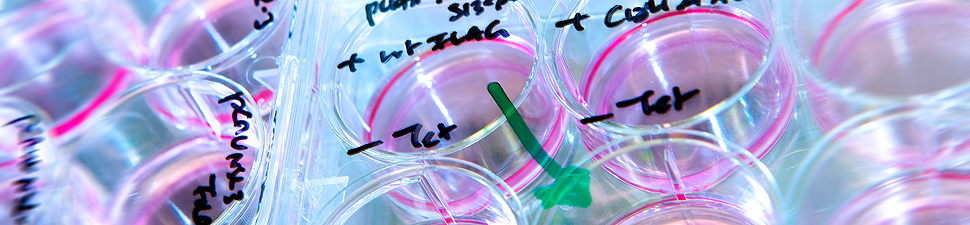

Le Département de médecine et le Département médecine de laboratoire et pathologie ont le plaisir de vous inviter à la Journée de la recherche. Voici…
Notre Service poursuit une activité de recherche fondamentale, translationnelle et clinique de visibilité internationale.
Les activités de recherche fondamentale de notre service se concentrent en premier lieu sur la virologie moléculaire et la pathogenèse des hépatites virales (plus d'informations), ainsi que les mécanismes immunologiques impliqués dans les maladies inflammatoires de l'intestin.
Nos chercheurs-euses sont aussi activement impliqué-e-s dans de nombreuses études cliniques nationales et internationales dans tous les domaines de la gastro-entérologie et de l'hépatologie, incluant la Swiss Hepatitis C Cohort Study et la Swiss IBD Cohort Study.
Chaque année, notre service publie dans la Revue médicale suisse une série d'articles de revue sur les avancées dans le domaine de la gestro-entérologie et l'hépatologie. Cette publication connaît un large succès non seulement en Suisse romande mais également au-delà de nos frontières.
Recherche fondamentale Recherche clinique & translationnelle Distinctions Publications Subsides
Le Département de médecine et le Département médecine de laboratoire et pathologie ont le plaisir de vous inviter à la Journée de la recherche. Voici…
La nutrition postopératoire après pancréatoduodénectomie reste un enjeu majeur en raison du risque élevé de complications et de dénutrition.